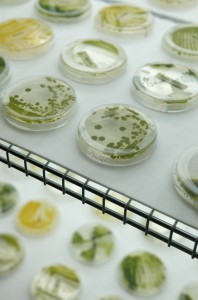
Different strains of algae shown at a Solazyme facility. CREDIT: AP Photo/Jeff Chiu

In December of 2015, nearly 200 nations met in Paris and agreed to hold global temperature increase well below 2 degrees Celsius. The agreement was widely lauded as an important first step in averting the catastrophic consequences of climate change, but came with its own set of caveats. For the world to truly stall temperature rise well below 2 degrees Celsius, every nation would need to make massive changes to their energy, transportation, and manufacturing sectors in the coming decades. Renewable energy would need to be deployed at a rate unseen before. Emissions would need to peak soon and then start to fall — and fast.
Meanwhile, meat consumption — a significant driver of global carbon emissions — is expected to rise dramatically in the near future, as advances in technology, trade liberalization, and population growth continue to expand the global economy. As countries become increasingly developed, demand for protein is one of the first things to increase.
And it’s not just rising emissions that threaten to gnaw at the margins of the global livestock industry. Livestock is a resource-intensive endeavor, with a pound of beef requiring roughly nine pounds of grain and 1,799 gallons of water. And with livestock grazing and feed production currently occupying nearly 80 percent of all agricultural land, there isn’t much space for the livestock industry to expand, either to meet increasing demand or adapt to decreasing resources.
All that leaves the livestock industry in a bit of a bind. How does one produce more meat with fewer inputs? A good place to start is with one of the most resource-intensive parts of the livestock production cycle: growing the feed, which accounts for about 45 percent of livestock’s total carbon footprint, due in large part to land use changes, fertilizers, and the machinery needed to produce feed crops like corn and soy.
But what if there were another source of livestock feed, that could grow in marginal land, without any fertilizers or extra water, and with a carbon footprint much smaller than corn or soy?
Recycling byproducts from biofuels
Algae — a diverse group of marine organisms that contains more than thirty thousand species — might not be the most instinctive place to look for a sustainable, nutritious livestock feed. Livestock, after all, are terrestrial creatures, whose historic tastes lean towards decidedly land-based foods like grass, grains, and hay. But livestock, and especially cattle, are hardly picky eaters.
“One of the things that make beef cattle so special is that they are some of our greatest recyclers,” Jason Smith, extension beef cattle specialist with the University of Tennessee told ThinkProgress. “They can take a product that would have to be dealt with as waste, and convert them into a product that is safe, wholesome, and valuable.”
One of the things that make beef cattle so special is that they are some of our greatest recyclers
For decades, that’s exactly what the livestock industry has been doing with distiller’s grains leftover from ethanol production, adding the byproducts to livestock feed to replace up to 20 percent of a cow’s diet. If those distiller’s grains weren’t going into livestock feed, Smith explains, they would likely be bound for a landfill. Replacing a portion of the cow’s diet with ethanol byproducts can also help cut down on the amount of cropland devoted to growing grain feed for cows, reducing the amount of fertilizer needed and lessening the environmental impact of things like nitrous oxide, a greenhouse gas that comes from nitrogen-based fertilizers, and nutrient runoff.
But corn isn’t the only plant that the biofuel industry has in its pocket. In the 1950s, researchers at MIT created the first mass-culture of microalgae on the rooftop of a campus building, and mentioned in their report that such microalgaes might one day provide the basis for biofuels. By the 1970s, energy shocks led to a renewed interest in algal-based biofuels, and since then, biofuel companies have been scrambling to make large-scale algal-based biofuels a realistic competitor to ethanol.
Thus far, algae-based biofuels have been slow to catch up to the scale of ethanol, due to a number of technological and financial hurdles. Namely, building facilities large enough to grow the amount of algae needed to create a viable biofuel industry is expensive — and with the price of oil so low, there’s little incentive for businesses to make that investment.
Locally-grown algae-fed beef?
Despite technological and financial barriers to commercial algal biofuels, the industry has been working for years with livestock producers to see if algal byproducts could be used in livestock feed, much in the same way that cattle producers currently use leftovers from ethanol production. But algae is a unique crop, and it has several properties that can make it a more sustainable alternative to corn-based ethanol. To start, it can grow in brackish water or non-agricultural land, which means that it can be grown on marginal land or water, instead using land that could grow food for human consumption. And algae requires no additional fertilizers, reducing the risk of nitrous oxide or nutrient runoff, each of which contribute to their own suite of environmental problems.
It is an opportunity to use land that is not productive from an agricultural standpoint…
“It is an opportunity to use land that is not productive from an agricultural standpoint or that cannot be used from a residential standpoint, and use that land to produce a feedstock for biofuel,” Smith said.
But as with ethanol, turning algae into biofuel leaves producers with a residual product that can’t be used as fuel. And so in 2012, Tryon Wickersham, an associate professor at Texas A&M; University, worked with the National Alliance for Advanced Biofuels and the Department of Energy to research the feasibility of using algal byproducts, leftover from producing algae-based biofuel for airplanes, as feed for livestock.
“As a scientist, it was exciting because it was a new thing, and there’s not a lot of new feed ingredients,” Wickersham said. “Livestock diets change, but they’ve all been grain and forage based for a long time. The concept that there would be a new ingredient was exciting.”
But Wickersham and his colleagues also approached the project with a level of skepticism, unsure if the biofuel industry really understood the scale necessary to provide enough algal-byproducts for livestock production, and unsure whether or not the cattle would take to the feed.
To start, Wickersham’s team looked at any potential harm that algal-byproducts could have on the animals. After conducting a routine nutrient analysis, they decided that it would be safe to feed to animals. Since the algal-byproducts were high in protein, the fuel had the most potential as protein supplement. There was some concern about palatability, since the product is inherently quite salty — Wickersham compared it to a bag of salted popcorn without water.

But when presented with the algae feed, the cattle seemed unfazed.
“They ate it, and performed really well,” Wickersham said. “It actually performed similarly to cottonseed oil, which is what we would normally feed for a protein supplement.”
Algae could never fully replace grass, grain, or silage in a cow’s diet. It doesn’t contain any roughage, which cows need to keep their stomachs from becoming too acidic. Because algal-byproducts are also high in fats, as well as sulfur, putting too much of them in a cow’s diet could tip the scale from a nutritious to dangerous.
Wickersham’s team also looked at how a diet comprised partially of algae products might influence the meat itself, and found that the algae actually improved meat quality slightly, resulting in a more richly marbled meat.
The primary hurdle, Wickersham said, is that of scale. With the price of oil so low, large commercial algae operations are more of a risk than proven technologies like ethanol.
“Terrestrial crops have a 10,000 year head start for being grown for human purposes,” Wickersham said. “We have a lot of technology that is set up to grow them, maintain them. For algae, it’s a scale and a knowledge issue. What’s the best way to harvest algae, what’s the best way to dry algae?”
Algae, the green feed
The low cost of oil means that, at least for the time being, large-scale algae to biofuel operations are unlikely to take off. So recently, companies have turned to algae as a food product, growing it to extract oils, powders, and flours that can be used as egg and oil replacements.
One company that has had success with this model is Solazyme, a San Francisco-based operation. Originally, Solazyme was created to capitalize on the algal biofuel market, but later shifted its focus to algal-based food products. In 2014, Solazyme partnered with Bunge, one of the world’s biggest commodity traders, to open a full-scale commercial plant in Brazil, which can produce up to 100,000 metric tons of algal oils per year.
With the expansion of their operation, Solazyme was faced with a new problem — what to do with the residual algal meal that is leftover after the oil is extracted from the microalgae.
“We’re trying to make sure that everything we use has a home, the oil as well as residual algal cells,” Walter Rakitsky, Solazyme’s senior director of business and strategy, told ThinkProgress. “Brazil has a huge animal agriculture industry and consumes lots and lots of feed, so there’s plenty of opportunities to use [the residual algal cells] locally.”
So Solazyme partnered with a handful of Brazilian cattle producers, selling them their leftover algal meal to use as replacement for some of their traditional livestock feed. And according to Eduardo de Palma, Solazyme’s business development director in Brazil, the cattle ate the algal byproducts up.

“It has proven to be a very good alternative in terms of feed, because it has good nutrition and protein levels — especially the high caloric level that comes from the carbohydrates that are contained in the cell walls, as well as the residual oil,” de Palma said. Moreover, cows seem to really enjoy the taste, which de Palma says resembles molasses, thanks to the sugars used to feed the algae.
The cattle ranchers were also quick to adapt to algae as a source of livestock feed.
“These feedlots were very receptive to trying the product,” he said. “They understood it was good for the cattle, it was a new source of a new feed that could be revolutionary, and they wanted to be the first to try it.”
Solazyme doesn’t anticipate algal byproducts being available to livestock producers in the United States anytime soon; there simply isn’t a facility in the United States that can produce the feed at the scale needed for livestock operations. But Rakitsky is hopeful that, as technology improves, those facilities will become a reality, and livestock producers will have the option of replacing some of their traditional land-based feed with algal-based products.
“As this technology matures and we get to larger and larger scale and higher and higher volumes, I think the future looks good,” he said. “We are very optimistic about the ability for microalgae ingredients to be more than just a very small part of an animal feed.”
The livestock industry, squeezed by the pressure to produce more meat with fewer resources, also sees potential in algal-based feed.
“The ultimate goal is to produce more feed for people with fewer inputs,” Wickersham said.
